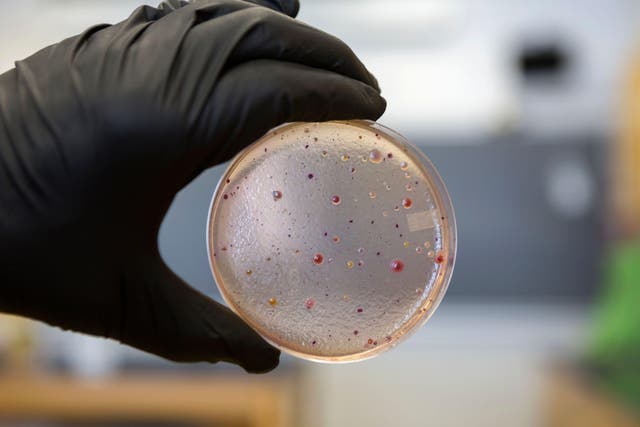
<p>An E.Coli infection can lead to a life-threatening form of kidney failure</p>

Stay up to date with notifications from The Independent
Notifications can be managed in browser preferences.
Thank you for registering
Please refresh the page or navigate to another page on the site to be automatically logged inPlease refresh your browser to be logged in
Health and Human Services
Thank you for registering
Please refresh the page or navigate to another page on the site to be automatically logged inPlease refresh your browser to be logged in